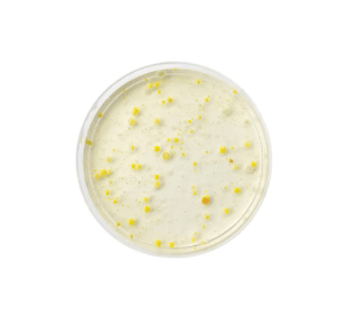

Strong Muscles. Healthier Joints. Happier Gut.
This all-in-one formula packs 26g of complete protein from grass-fed whey, bone broth, A2/A2 milk protein, collagen peptides, and colostrum—plus enzymes and probiotics for better digestion. It supports lean body mass*, muscle strength, joint health, and post-exercise recovery.
Preferred Customer Offer:
Save Over 25%
and Support TBN!
Free & Fast Shipping!
Your purchase supports TBN Worldwide Ministries


Buy with confidence when purchasing from Ancient Nutrition with our *30-day money-back guarantee. We even pay for the return shipping when you provide an email.
We’ve officially raised the bar for animal-based protein. Multi Protein Animal-Based is a science-backed formula designed to support your muscles, joints and gut health. Each scoop delivers 26g of complete protein from five functional sources: grass-fed whey, bone broth, A2/A2 milk protein, collagen peptides, and grass-fed colostrum. Together, they provide all 9 essential amino acids, and collagen peptides to fuel muscle health, improve recovery, and support more comfortable joints.
For one daily scoop that supports your muscles, joints, and a balanced microbiome, choose Multi Protein Animal-Based. It’s a science-backed formula that can help you promote muscle health, efficient protein breakdown, reduce bloating and modulate your gut microbiome. Talk about a multitasker.

Features That Matter
Supports muscle health†
Supports lean body mass (with resistance training)†
Supports skin hydration, firmness, and elasticity†
Improves skin texture and overall skin quality†
Promotes a youthful appearance and reduces visible signs of aging†
Supports healthier, stronger hair texture and quality†
Supports joint comfort and mobility†
Helps reduce occasional joint stiffness and discomfort†
Improves joint function and flexibility†
Supports comfort during joint movement†
Supports a more efficient breakdown of protein†
Supports digestive health†
Reduces occasional bloating and gas†
Supports GI comfort and wellbeing†
Supports healthy movement through the digestive tract†
Encourages a healthy balance of gut bacteria†

AVAILABLE IN DARK CHOCOLATE & VANILLA BEAN!
Build lean body mass and muscle strength, support joint comfort, improve recovery, and boost gut health with a multi-source protein designed to help you feel stronger, move better, and perform your best every day.
A unique blend of enzymes and probiotics supports smooth digestion, GI comfort, and well-being, and less bloating and gas.
Real Ingredients


Creatine Monohydrate

Our unique Protein Digestion† Blend features protease, a digestive enzyme that helps break down protein into smaller peptides—so your body actually gets the full benefit of every scoop. It’s paired with Bacillus coagulans, a clinically studied probiotic shown to support gut comfort, reduce occasional bloating and promote a healthy gut microbiome. Together, they help make this formula easier to digest so you can reap the benefits.

Look Lean. Get Strong.
Think Fast.
Get the performance benefits of whey and creatine with the power of collagen, bone broth, and colostrum. Designed for full-body results — without the bloat or chalky taste of typical protein powders.
This is a performance-driven formula designed to go beyond your basic protein powder. Multi Protein Animal-Based delivers 26g of complete protein from grass-fed whey, bone broth, A2/A2 milk protein, collagen peptides, and colostrum – all chosen for their quality and effectiveness. Together, these ingredients deliver a complete protein that supports muscle, joint health, post-workout recovery and gut function in each powerful scoop. And – thanks to a Protein Digestion† Blend of protease and Bacillus coagulans – this protein is designed to be easy-to-digest and gut-friendly. Whether you're training hard or optimizing your everyday routine, this is protein that works as hard as you do.






Real People, Real Reviews


I love this product. It has multiple great nutritious things plus it's fulfilling taste great and I'm getting amazing benefits. I will tell everyone I know about this product.
Norma B.
01/03/26 Verified Buyer


I loooove the Chocolate one but wish it was a lil more chocolaty and also woyld be a 30 day canister, but I like that it doesn't feel heavy or thick!!
Sandra W.
12/28/25 Verified Buyer


This product tastes great and has great ingredients! I add it to my morning smoothie. But I don’t use the scoop as it is quite large. Plus I still have some of the individual ingredients right now.
Laurie M.
12/25/25 Verified Buyer


This product tastes SO good! Easily the best tasting protein I've tried to date. Also love that I no longer need to add a dozen different powders to my morning smoothie. Thank you Ancient Nutrition - this is my dream product!!
Maggie
12/22/25 Verified Buyer


It tastes delicious and takes the guess work of what to put in my smoothie. Having the creatine in there ensures I never forget to take it! Love this product !
Kate D.
12/19/25 Verified Buyer


This product has everything I need in 1 scoop. I love that it is a compete protein + has collagen, colostrum and creatine. It tastes great too - I love using it in a smoothie
Sarah
12/19/25 Verified Buyer

Buy with confidence when purchasing from Ancient Nutrition with our *30-day money-back guarantee. We even pay for the return shipping when you provide an email.
Select Your Offer Below!
A Substantial Portion of your purchase will be given back to TBN to support their worldwide ministry.






